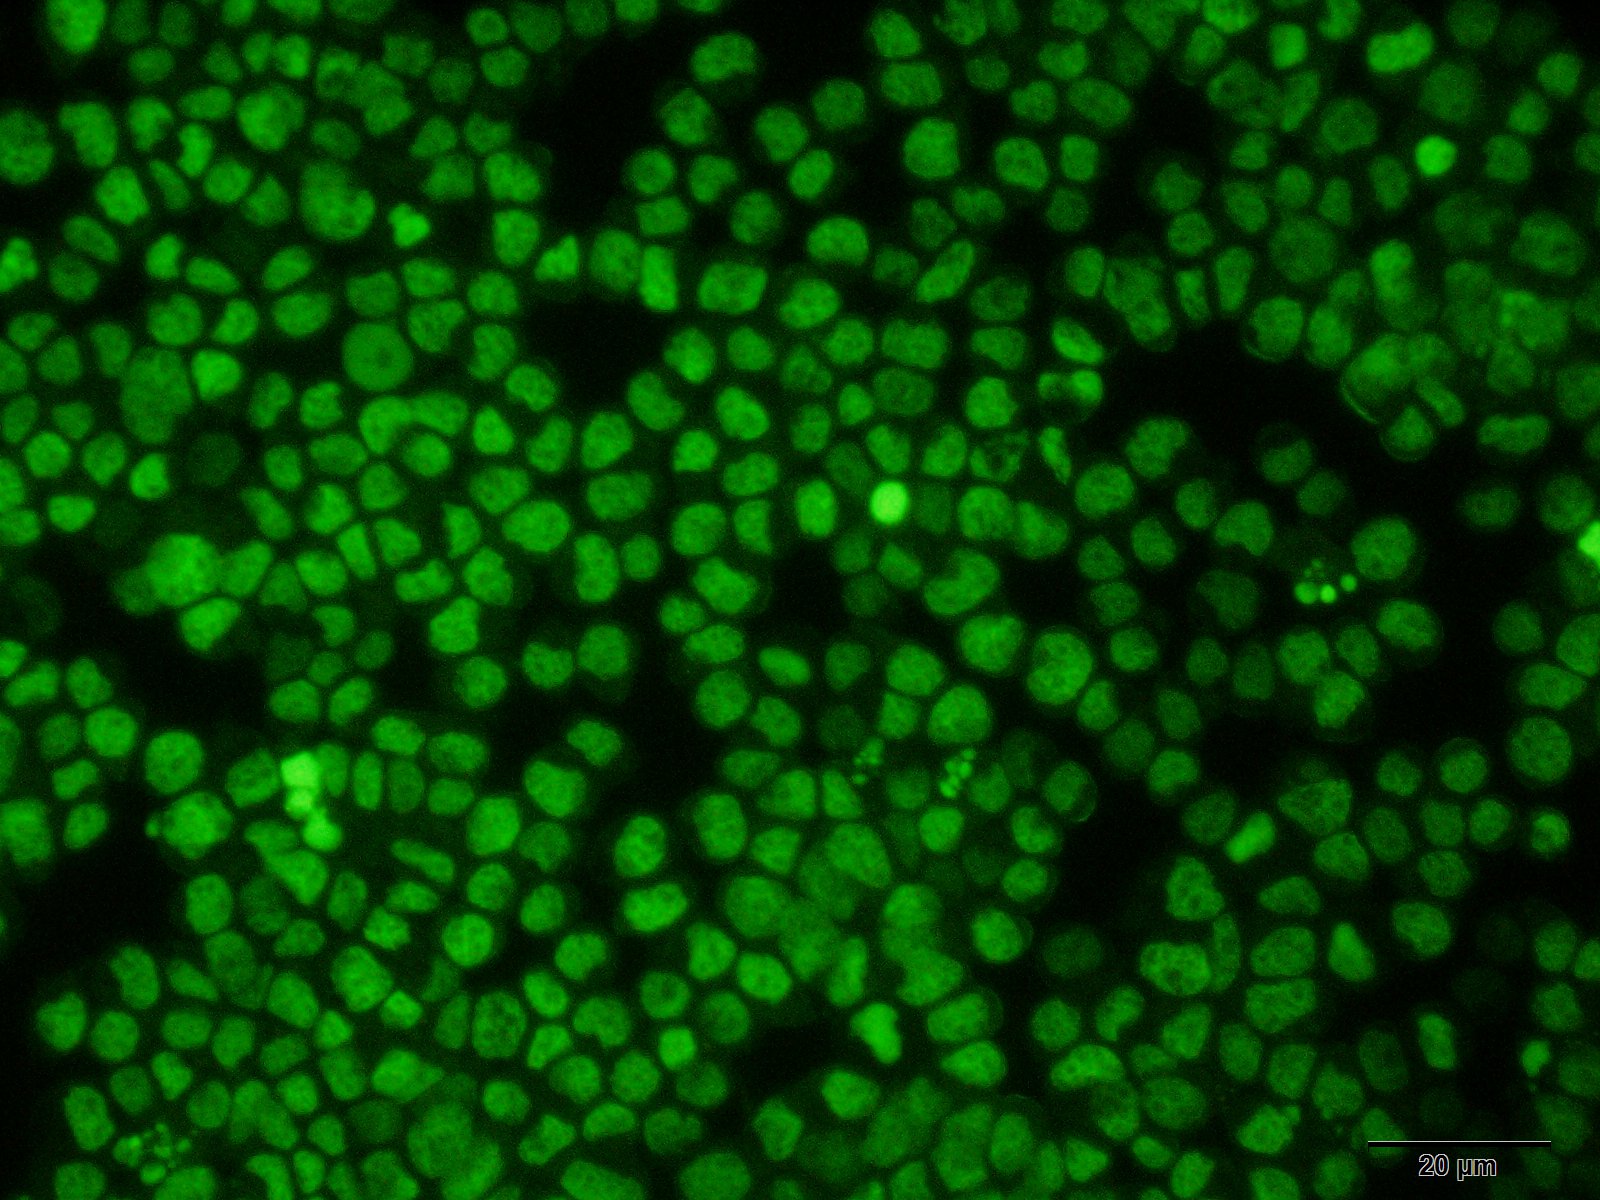

Introduction To Order Documents Related Products Introduction NucTracer™ red live-cell nucleic acid stain is a cell-permeant red fluorescent stain exhibits bright, red fluorescence upon binding to nucleic acids. This dye is provided as 1 mM solution in DMSO. Specifications: Excitation/Emission: 640/660 nm Shipping Condition: Ambient Storage Conditions: -20ºC, protect from light Molecular Formula: N/A Molecular Weight: N/A […]
Continue Reading